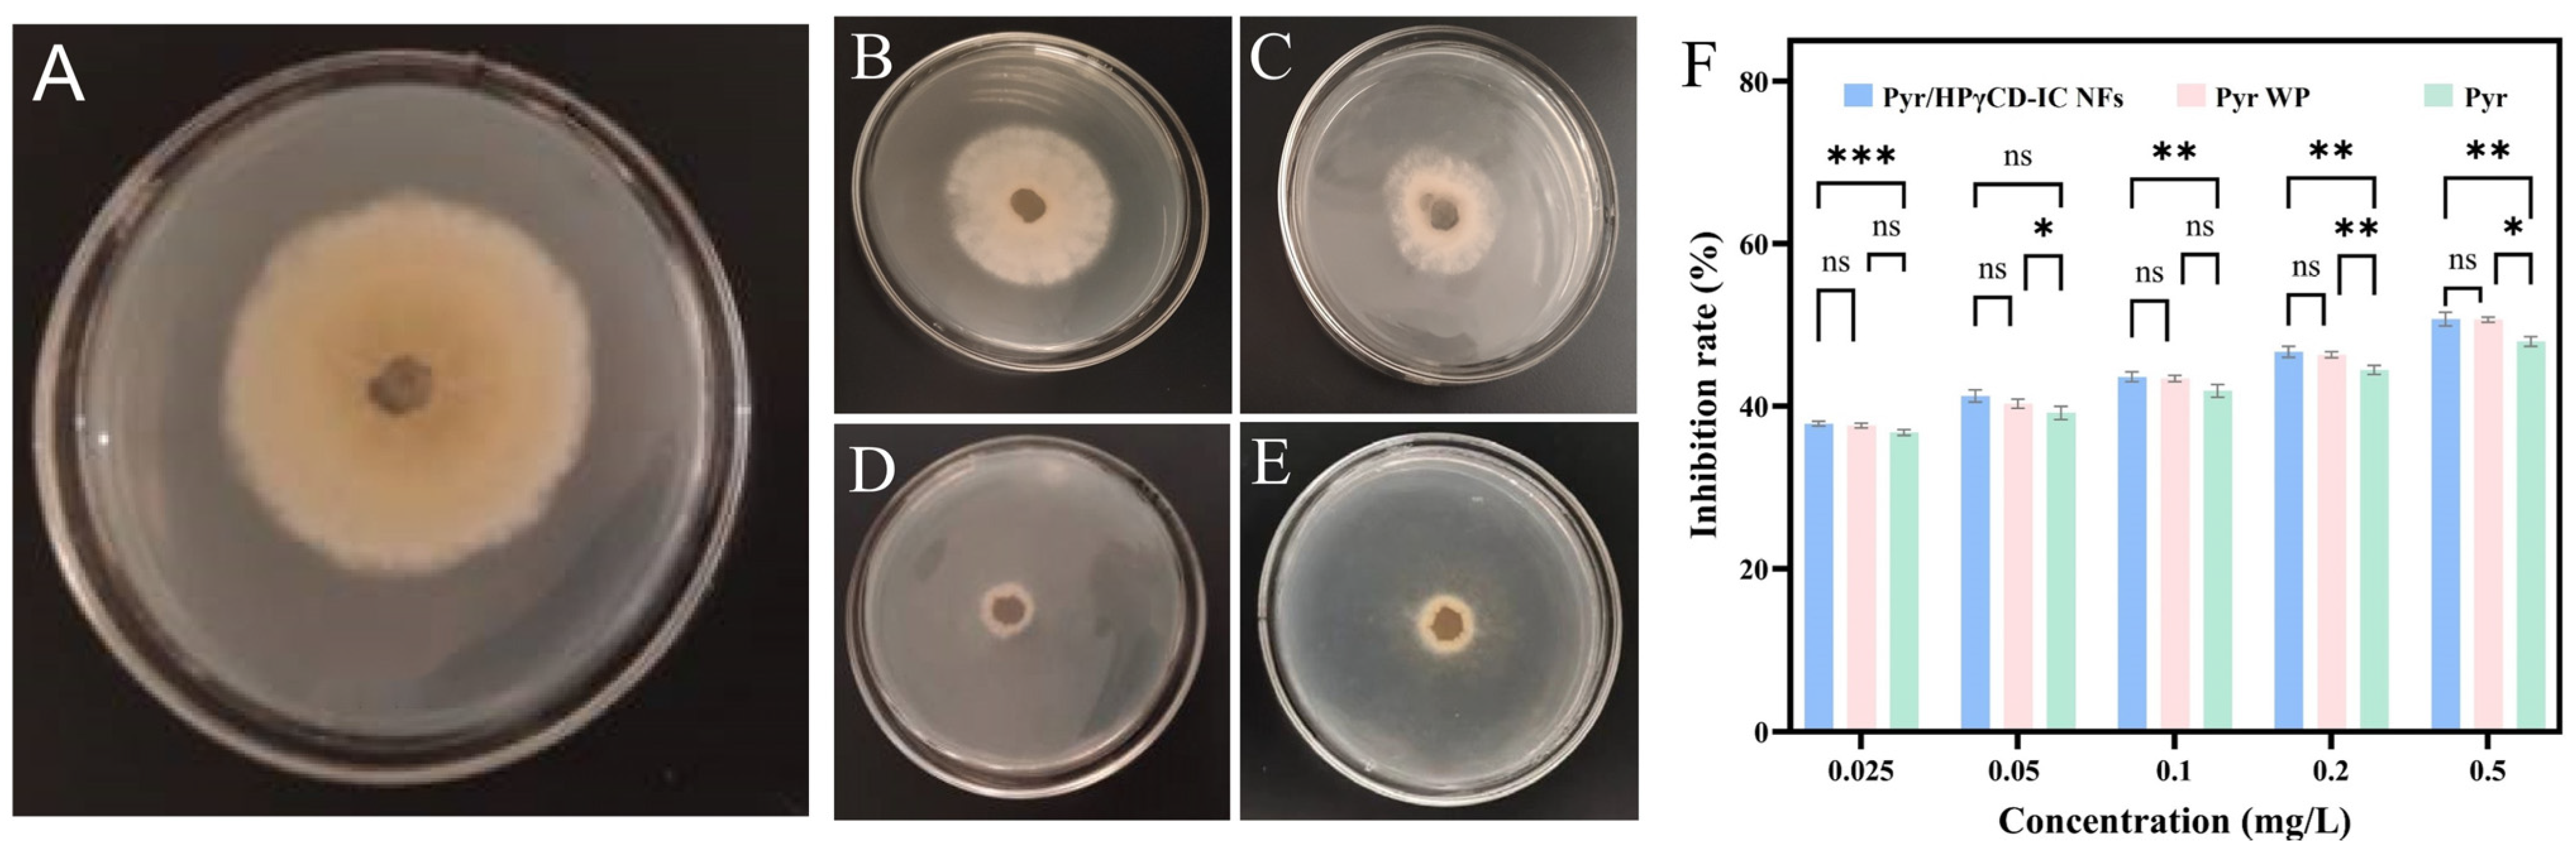
Molecules 30 01456 g009

Electrospun Nanofibers Incorporated with HPγCD Inclusion Complex for Improved Water Solubility and Activity of Hydrophobic Fungicides Pyrimethanil
Abstract
1. Introduction
2. Results and Discussion
2.1. Morphology Analysis
2.2. Analysis of FT-IR Spectrum
2.3. XRD Analysis
2.4. TGA Analysis
2.5. 1H NMR Spectrum Studies
2.6. Phase Solubility Studies
2.7. Determination of Dissolved Effect
2.8. Molecular Modeling
2.9. Antifungal Test Analysis
3. Materials and Methods
3.1. Materials
3.2. Preparation of Solutions for Electrospinning
3.3. Preparation of Electrospinning Nanofibers
3.4. Preparation of Pyr/HPγCD Inclusion Complex Solid
3.5. Preparation of Pyrimethanil-HPγCD Physical Mixture
3.6. Measurements and Characterization
3.6.1. Morphology Analysis
3.6.2. FT-IR Analysis
3.6.3. XRD Study
3.6.4. Analysis of Thermal Stability
3.6.5. 1H NMR Analysis
3.6.6. Phase Solubility Study
3.6.7. Rapid Dissolution Experiment
3.6.8. Molecular Simulation
3.6.9. Antifungal Activity
3.6.10. Statistical Analysis
4. Conclusions
Author Contributions
Funding
Institutional Review Board Statement
Informed Consent Statement
Data Availability Statement
Conflicts of Interest
References
- Zhou, J.; Liu, G.Y.; Guo, Z.J.; Wang, M.; Qi, C.Y.; Chen, G.; Huang, X.D.; Yan, S.; Xu, D.H. Stimuli-responsive pesticide carriers based on porous nanomaterials: A review. Chem. Eng. J. 2023, 455, 140167. [Google Scholar]
- Singh, R.P.; Handa, R.; Manchanda, G. Nanoparticles in sustainable agriculture: An emerging opportunity. J. Control. Release 2021, 329, 1234–1248. [Google Scholar] [CrossRef] [PubMed]
- Li, N.J.; Sun, C.J.; Jiang, J.J.; Wang, A.Q.; Wang, C.; Shen, Y.; Huang, B.N.; An, C.C.; Cui, B.; Zhao, X.; et al. Advances in controlled-release pesticide formulations with improved efficacy and targetability. J. Agric. Food Chem. 2021, 69, 12579–12597. [Google Scholar]
- He, C.Y.; Wu, T.Y.; Li, J.; Zhang, X.Y.; Zheng, Z.R.; Gao, Y.X.; Zhang, C.H.; Zhong, T.J.; Zhang, Y.F.; Du, F.P. Bio-stimulant based nanodelivery system for pesticides with high adhesion and growth stimulation. Chem. Eng. J. 2024, 491, 151904. [Google Scholar]
- Zhou, Q.; Xia, Z.; Zhang, Y.; Sun, Z.L.; Zeng, W.; Zhang, N.; Yuan, C.M.; Gong, C.Y.; Zhou, Y.X.; Xue, W. Design of a delivery vehicle chitosan-based self-assembling: Controlled release, high hydrophobicity, and safe treatment of plant fungal diseases. J. Nanobiotechnol. 2024, 22, 121. [Google Scholar] [CrossRef]
- Zhao, K.F.; Xu, G.C.; Wang, L.; Wu, T.Y.; Zhang, X.Y.; Zhang, C.H.; Zhao, Y.H.; Li, Z.L.; Gao, Y.X.; Du, F.P. Using a dynamic hydrophilization strategy to achieve nanodispersion, full wetting, and precise delivery of hydrophobic pesticide. Acs Appl. Mater. Interfaces 2023, 15, 37093–37106. [Google Scholar]
- An, C.C.; Huang, B.N.; Jiang, J.J.; Wang, X.Y.; Li, N.J.; Liu, H.H.; Shen, Y.; Sun, C.J.; Zhan, S.S.; Li, X.Y.; et al. Design and synthesis of a water-based nanodelivery pesticide system for improved efficacy and safety. Acs Nano 2023, 18, 662–679. [Google Scholar]
- An, C.C.; Sun, C.J.; Li, N.J.; Huang, B.N.; Jiang, J.J.; Shen, Y.; Wang, C.; Zhao, X.; Cui, B.; Wang, C.X.; et al. Nanomaterials and nanotechnology for the delivery of agrochemicals: Strategies towards sustainable agriculture. J. Nanobiotechnol. 2022, 20, 11. [Google Scholar]
- Song, S.J.; Jiang, X.F.; Shen, H.; Wu, W.N.; Shi, Q.Q.; Wan, M.H.; Zhang, J.; Mo, H.; Shen, J. MXene (Ti3C2) based pesticide delivery system for sustained release and enhanced pest control. ACS Appl. Bio Mater. 2021, 4, 6912–6923. [Google Scholar]
- Zhao, M.; Zhou, H.J.; Hao, L.; Chen, H.Y.; Zhou, X.H. A high-efficient nano pesticide-fertilizer combination fabricated by amino acid-modified cellulose based carriers. Pest Manag. Sci. 2022, 78, 506–520. [Google Scholar]
- Das, K.P.; Singh, P.; Satapathy, B.K. Nanofibrous-substrate-based controlled herbicidal release systems: Atrazine/hydroxypropyl-β-cyclodextrin inclusion complex loaded PVA agro-augmenting electrospun mats. J. Environ. Chem. Eng. 2023, 11, 111586. [Google Scholar] [CrossRef]
- Wang, C.X.; Wang, M.J.; Wang, Y.; Pan, J.Q.; Sun, C.J.; Zeng, Z.H.; Ren, S.K.; Cui, H.X.; Zhao, X. Construction and characterization of novel hydrophilic nanospheres loaded with lambda-cyhalothrin via ultrasonic emulsification-solvent evaporation. Int. J. Mol. Sci. 2022, 23, 14063. [Google Scholar] [CrossRef] [PubMed]
- Riseh, R.S.; Hassanisaadi, M.; Vatankhah, M.; Varma, R.S.; Thakur, V.K. Nano/micro-structural supramolecular biopolymers: Innovative networks with the boundless potential in sustainable agriculture. Nano-Micro Lett. 2024, 16, 147. [Google Scholar] [CrossRef] [PubMed]
- Liu, Z.J.; Ye, L.; Xi, J.N.; Wang, J.; Feng, Z.G. Cyclodextrin polymers: Structure, synthesis, and use as drug carriers. Prog. Polym. Sci. 2021, 118, 101408. [Google Scholar] [CrossRef]
- Li, W.J.; Xu, W.W.; Zhang, S.Y.; Li, J.; Zhou, J.; Tian, D.M.; Cheng, J.; Li, H.B. Supramolecular biopharmaceutical carriers based on host-guest interactions. J. Agric. Food Chem. 2022, 70, 12746–12759. [Google Scholar] [CrossRef]
- Yang, G.; Li, F.R.; Zhang, H.R.; Yan, H.L.; Gao, S.; Fu, Y.; Ye, F. Electrospinning for producing antifungal nanofibers consisting of prochloraz/hydroxypropyl-γ-cyclodextrin inclusion complex. Ind. Crops Prod. 2024, 211, 118282. [Google Scholar] [CrossRef]
- Peng, Q.; Luo, X.M.; Su, J.R.; Bi, Y.G.; Kong, F.S.; Wang, Z.; Tan, S.F.; Zhang, J.Y. Microencapsulation of star anise essential oil: Preparation, characterization, in vitro digestion, and biological activity. Colloids Surf. A-Physicochem. Eng. Asp. 2024, 696, 134358. [Google Scholar] [CrossRef]
- Crini, G. Review: A history of cyclodextrins. Chem. Rev. 2014, 114, 10940–10975. [Google Scholar] [CrossRef]
- Feng, W.W.; Guo, X.Y.; Yang, G.; Yao, Y.; Zhao, L.X.; Gao, S.; Ye, F.; Fu, Y. Direct electrospinning for producing multiple activity nanofibers consisting of aggregated luteolin/hydroxypropyl-gamma-cyclodextrin inclusion complex. Int. J. Biol. Macromol. 2024, 270, 132344. [Google Scholar] [CrossRef]
- Keirouz, A.; Wang, Z.; Reddy, V.S.; Nagy, Z.K.; Vass, P.; Buzgo, M.; Ramakrishna, S.; Radacsi, N. The history of electrospinning: Past, present, and future developments. Adv. Mater. Technol. 2023, 8, 2201723. [Google Scholar] [CrossRef]
- Shangguan, W.J.; Li, S.Q.; Cao, L.D.; Wei, M.; Wang, Z.S.; Xu, H.L. Electrospinning and nanofibers: Building drug delivery systems and potential in pesticide delivery. Mater. Today Commun. 2022, 33, 104399. [Google Scholar] [CrossRef]
- Zhang, C.; Li, Y.; Wang, P.; Zhang, H. Electrospinning of nanofibers: Potentials and perspectives for active food packaging. Compr. Rev. Food Sci. Food Saf. 2020, 19, 479–502. [Google Scholar] [PubMed]
- Hu, X.L.; Liu, S.; Zhou, G.Y.; Huang, Y.B.; Xie, Z.G.; Jing, X.B. Electrospinning of polymeric nanofibers for drug delivery applications. J. Control. Release 2014, 185, 12–21. [Google Scholar]
- Celebioglu, A.; Uyar, T. Electrospinning of nanofibers from non-polymeric systems: Polymer-free nanofibers from cyclodextrin derivatives. Nanoscale 2012, 4, 621–631. [Google Scholar] [PubMed]
- Kali, G.; Haddadzadegan, S.; Bernkop-Schnürch, A. Cyclodextrins and derivatives in drug delivery: New developments, relevant clinical trials, and advanced products. Carbohydr. Polym. 2024, 324, 121500. [Google Scholar] [CrossRef]
- Hsiung, E.; Celebioglu, A.; Kilic, M.E.; Durgun, E.; Uyar, T. Ondansetron/Cyclodextrin inclusion complex nanofibrous webs for potential orally fast-disintegrating antiemetic drug delivery. Int. J. Pharm. 2022, 623, 121921. [Google Scholar]
- Gao, S.; Li, X.M.; Yang, G.; Feng, W.W.; Zong, L.; Zhao, L.X.; Ye, F.; Fu, Y. Antibacterial perillaldehyde/hydroxypropyl-γ-cyclodextrin inclusion complex electrospun polymer-free nanofiber: Improved water solubility, thermostability, and antioxidant activity. Ind. Crops Prod. 2022, 176, 114300. [Google Scholar]
- Akhavan-Mahdavi, S.; Mirbagheri, M.S.; Assadpour, E.; Sani, M.A.; Zhang, F.Y.; Jafari, S.M. Electrospun nanofiber-based sensors for the detection of chemical and biological contaminants/hazards in the food industries. Adv. Colloid Interface Sci. 2024, 325, 103111. [Google Scholar]
- Wang, Z.W.; Wang, X.Q.; Cang, T.; Zhao, X.P.; Wu, S.G.; Qi, P.P.; Wang, X.Y.; Xu, X.H.; Wang, Q. Positive effects of an oil adjuvant on efficacy, dissipation and safety of pyrimethanil and boscalid on greenhouse strawberry. Ecotoxicol. Environ. Saf. 2018, 160, 127–133. [Google Scholar]
- Hu, G.X.; Li, J.X.; Wang, Z.T.; Yang, W.E.; Hu, Y.H. PCL/Yam Polysaccharide nanofibrous membranes loaded with self-assembled HP-13-CD/ECG inclusion complexes for food packaging. Food Chem. 2024, 438, 138031. [Google Scholar]
- Celebioglu, A.; Umu, O.; Tekinay, T.; Uyar, T. Antibacterial electrospun nanofibers from triclosan/cyclodextrin inclusion complexes. Colloids Surf. b-Biointerfaces 2014, 116, 612–619. [Google Scholar] [CrossRef] [PubMed]
- Celebioglu, A.; Uyar, T. Fast-dissolving antioxidant curcumin/cyclodextrin inclusion complex electrospun nanofibrous webs. Food Chem. 2020, 317, 126397. [Google Scholar] [CrossRef] [PubMed]
- Mura, P. Analytical techniques for characterization of cyclodextrin complexes in the solid state: A review. J. Pharm. Biomed. Anal. 2015, 113, 226–238. [Google Scholar] [CrossRef] [PubMed]
- Liu, B.; Duan, J.H.; Zhang, Y.H.; Wang, R.C.; Zhao, L.X.; Gao, S.; Ye, F.; Fu, Y. Preparation and characterization of hexaconazole/hydroxypropyl-gamma-cyclodextrin inclusion complex nanofibers for sustainable agriculture: Improved physicochemical properties and antifungal activity of hexaconazole. J. Mol. Struct. 2024, 1299, 137195. [Google Scholar] [CrossRef]
- Sharif, N.; Golmakani, M.T.; Hajjari, M.M.; Aghaee, E.; Ghasemi, J.B. Antibacterial cuminaldehyde/hydroxypropyl-β-cyclodextrin inclusion complex electrospun fibers mat: Fabrication and characterization. Food Packag. Shelf Life 2021, 29, 100738. [Google Scholar] [CrossRef]
- Aytac, Z.; Celebioglu, A.; Yildiz, Z.I.; Uyar, T. Efficient encapsulation of citral in fast-dissolving polymer-free electrospun nanofibers of cyclodextrin inclusion complexes: High thermal stability, longer shelf-Life, and enhanced water solubility of citral. Nanomaterials 2018, 8, 793. [Google Scholar] [CrossRef]
- Higuchi, T.; Connors, K.A. Phase solubility techniques. Adv. Anal. Chem. Instrum. 1965, 4, 56–63. [Google Scholar]
- Chandra, A.; Ghate, M.V.; Aithal, K.S.; Lewis, S.A. In silico prediction coupled with in vitro experiments and absorption modeling to study the inclusion complex of telmisartan with modified beta-cyclodextrin. J. Incl. Phenom. Macrocycl. Chem. 2018, 91, 47–60. [Google Scholar] [CrossRef]
- Gao, S.; Jiang, J.Y.; Li, X.M.; Ye, F.; Fu, Y.; Zhao, L.X. Electrospun polymer-free nanofibers incorporating hydroxypropyl-β-cyclodextrin/difenoconazole via supramolecular assembly for antifungal activity. J. Agric. Food Chem. 2021, 69, 5871–5881. [Google Scholar] [CrossRef]
- Zhang, Y.H.; Li, F.R.; Guo, G.H.; Xiu, Y.; Yan, H.L.; Zhao, L.X.; Gao, S.; Ye, F.; Fu, Y. Preparation and characterization of betulin/methyl-beta-cyclodextrin inclusion complex electrospun nanofiber: Improving the properties of betulin. Ind. Crops Prod. 2024, 209, 117974. [Google Scholar] [CrossRef]
- Celebioglu, A.; Uyar, T. Electrospun formulation of acyclovir/cyclodextrin nanofibers for fast-dissolving antiviral drug delivery. Mater. Sci. Eng. c-Mater. Biol. Appl. 2021, 118, 111514. [Google Scholar] [CrossRef] [PubMed]
- Gao, S.; Liu, Y.Y.; Jiang, J.Y.; Li, X.M.; Ye, F.; Fu, Y.; Zhao, L.X. Thiram/hydroxypropyl-β-cyclodextrin inclusion complex electrospun nanofibers for a fast dissolving water-based drug delivery system. Colloids Surf. B-Biointerfaces 2021, 201, 111625. [Google Scholar] [CrossRef] [PubMed]
- Wang, Z.; Zou, W.; Liu, L.Y.; Wang, M.; Li, F.; Shen, W.Y. Characterization and bacteriostatic effects of β-cyclodextrin/quercetin inclusion compound nanofilms prepared by electrospinning. Food Chem. 2021, 338, 127980. [Google Scholar] [CrossRef]
- Celebioglu, A.; Uyar, T. Development of ferulic acid/cyclodextrin inclusion complex nanofibers for fast -dissolving drug delivery system. Int. J. Pharm. 2020, 584, 119395. [Google Scholar] [CrossRef]
- Gao, S.; Zong, L.; Zhang, Y.H.; Zhang, Y.; Guo, X.Y.; Guo, G.H.; Zhao, L.X.; Ye, F.; Fu, Y. Antifungal pentachloronitrobenzene/hydroxypropyl-beta-cyclodextrin inclusion complex nanofibers by electrospun with no polymer: Fabrication and characterization. J. Clean. Prod. 2023, 413, 137499. [Google Scholar] [CrossRef]

| Chemical Shift (δ) | ||||||||
|---|---|---|---|---|---|---|---|---|
| OCH2 | H-1 | HOC H2 | H-3 | H-5 | H-4 | H-2 | CH3 | |
| HPγCD | 5.79 | 5.12 | 4.88 | 4.61 | 3.75 | 3.63 | 2.51 | 1.03 |
| Pyr/HPγCD NFs | 5.81 | 5.09 | 4.88 | 4.59 | 3.74 | 3.62 | 2.51 | 1.03 |
| ∆δ | −0.03 | 0.03 | 0.00 | −0.02 | −0.01 | −0.01 | 0.00 | 0.00 |
| Chemical Shift (δ) | ||||||||
| H-a | H-b | H-c | H-d | H-e | H-f | |||
| Pyr | 9.47 | 7.82 | 7.26 | 6.91 | 6.59 | 2.31 | ||
| Pyr/HPγCD NFs | 9.47 | 7.82 | 7.25 | 6.90 | 6.62 | 2.31 | ||
| Δδ | 0.00 | 0.00 | −0.01 | −0.01 | 0.03 | 0.00 | ||
| Samples | Toxicological Equation | Correlation Coefficient (R) | EC50 (μg/mL) | Increased Multiple |
|---|---|---|---|---|
| Pyr | Y = 0.2207x + 5.0161 | 0.9999 | 0.840 | - |
| Pyr WP | Y = 0. 2507x + 5.0848 | 0.9997 | 0.459 | 1.84 |
| Pyr/HPγCD-IC- NFs | Y = 0.2485x + 5.0893 | 0.9999 | 0.437 | 1.92 |
Disclaimer/Publisher’s Note: The statements, opinions and data contained in all publications are solely those of the individual author(s) and contributor(s) and not of MDPI and/or the editor(s). MDPI and/or the editor(s) disclaim responsibility for any injury to people or property resulting from any ideas, methods, instructions or products referred to in the content. |
© 2025 by the authors. Licensee MDPI, Basel, Switzerland. This article is an open access article distributed under the terms and conditions of the Creative Commons Attribution (CC BY) license (https://creativecommons.org/licenses/by/4.0/).
Share and Cite
Gao, S.; Yan, H.; Xiu, Y.; Li, F.; Zhang, Y.; Wang, R.; Zhao, L.; Ye, F.; Fu, Y. Electrospun Nanofibers Incorporated with HPγCD Inclusion Complex for Improved Water Solubility and Activity of Hydrophobic Fungicides Pyrimethanil. Molecules 2025, 30, 1456. https://doi.org/10.3390/molecules30071456
Gao S, Yan H, Xiu Y, Li F, Zhang Y, Wang R, Zhao L, Ye F, Fu Y. Electrospun Nanofibers Incorporated with HPγCD Inclusion Complex for Improved Water Solubility and Activity of Hydrophobic Fungicides Pyrimethanil. Molecules. 2025; 30(7):1456. https://doi.org/10.3390/molecules30071456
Chicago/Turabian StyleGao, Shuang, Honglei Yan, Yue Xiu, Fengrui Li, Yu Zhang, Ruichi Wang, Lixia Zhao, Fei Ye, and Ying Fu. 2025. "Electrospun Nanofibers Incorporated with HPγCD Inclusion Complex for Improved Water Solubility and Activity of Hydrophobic Fungicides Pyrimethanil" Molecules 30, no. 7: 1456. https://doi.org/10.3390/molecules30071456
APA StyleGao, S., Yan, H., Xiu, Y., Li, F., Zhang, Y., Wang, R., Zhao, L., Ye, F., & Fu, Y. (2025). Electrospun Nanofibers Incorporated with HPγCD Inclusion Complex for Improved Water Solubility and Activity of Hydrophobic Fungicides Pyrimethanil. Molecules, 30(7), 1456. https://doi.org/10.3390/molecules30071456

